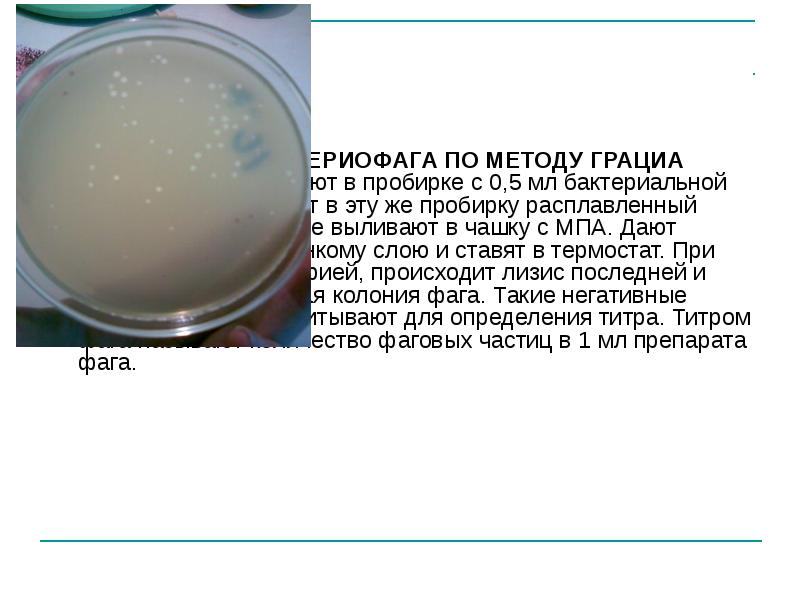

Определение фагов
Viewsonic 4
Обрести вариант
Оригинальные открытки любимому
Взаимопонимание между родителями и детьми сочинение
Девушки в обтянутом трико
Кроссворд ручной инструмент
Спортлото 8
Секция охотничьих спаниелей
Метла метла метла 12
Боев ударение
Юа юа юа песня
Старший по классу
Евангелион 3.0 ты не исправишь
Определение фагов 88 фото